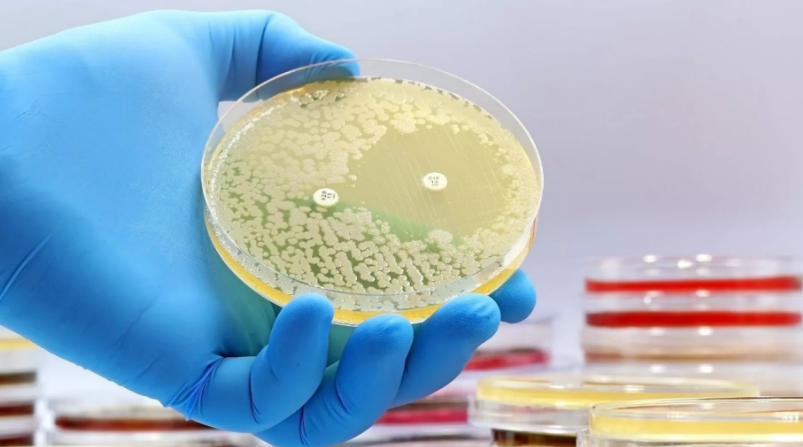

Një klasë e re e antibiotikëve për bakteret Staphylococcus aureus (MRSA) rezistente ndaj ilaçeve, u zbulua duke përdorur modele më transparente të të mësuarit të thellë.
Përdorimi i inteligjencës artificiale (AI) po provon të jetë një ndryshim i lojës kur bëhet fjalë për mjekësinë me teknologjinë që tani i ndihmon shkencëtarët të zbulojnë antibiotikët e parë të rinj në 60 vjet.
Zbulimi i një përbërësi të ri që mund të vrasë një bakter rezistent ndaj ilaçeve që vret mijëra njerëz në mbarë botën çdo vit, mund të jetë një pikë kthese në luftën kundër rezistencës ndaj antibiotikëve.
“Perceptimet këtu ishin se ne mund të shihnim se çfarë po mësohej nga modelet për të bërë parashikimet e tyre se molekula të caktuara do të bënin antibiotikë të mirë,” tha James Collins, profesor i Inxhinierisë Mjekësore dhe Shkencës në Institutin e Teknologjisë në Massachusetts (MIT) dhe një nga autorët e studimit, thuhet në një deklaratë.
“Puna jonë ofron një kornizë që është efikase për kohën, burimet efikase dhe mekanikisht depërtuese, nga pikëpamja e strukturës kimike, në mënyra që nuk kemi pasur deri më sot”.
Rezultatet u publikuan në Nature dhe kanë bashkëautor nga një ekip prej 21 studiuesish.
Studimi kishte për qëllim ‘hapjen e kutisë së zezë’
Ekipi që qëndron pas projektit përdori një model të të mësuarit të thellë për të parashikuar aktivitetin dhe toksicitetin e përbërjes së re.
Të mësuarit e thellë përfshin përdorimin e rrjeteve nervore artificiale për të mësuar dhe përfaqësuar automatikisht veçoritë nga të dhënat pa programim të qartë.
Ajo po aplikohet gjithnjë e më shumë në zbulimin e barnave për të përshpejtuar identifikimin e kandidatëve të mundshëm të barnave, për të parashikuar vetitë e tyre dhe për të optimizuar procesin e zhvillimit të barnave.
Në këtë rast, studiuesit u fokusuan në Staphylococcus aureus rezistent ndaj meticilinës (MRSA).
Infeksionet me MRSA mund të variojnë nga infeksione të lehta të lëkurës deri në kushte më të rënda dhe potencialisht kërcënuese për jetën, si pneumonia dhe infeksionet e qarkullimit të gjakut.
Pothuajse 150,000 infeksione MRSA ndodhin çdo vit në Bashkimin Evropian, ndërsa pothuajse 35,000 njerëz vdesin çdo vit në bllok nga infeksionet rezistente ndaj antimikrobikeve, sipas Qendrës Evropiane për Parandalimin dhe Kontrollin e Sëmundjeve (ECDC).
Ekipi i studiuesve të MIT trajnoi një model të zgjeruar gjerësisht të të mësuarit të thellë duke përdorur grupe të dhënash të zgjeruara.
Për të krijuar të dhënat e trajnimit, rreth 39,000 përbërës u vlerësuan për aktivitetin e tyre antibiotik kundër MRSA. Më pas, të dhënat rezultuese dhe detajet në lidhje me strukturat kimike të komponimeve u futën në model.
“Ajo që ne vendosëm të bënim në këtë studim ishte të hapnim kutinë e zezë. Këto modele përbëhen nga një numër shumë i madh llogaritjesh që imitojnë lidhjet nervore dhe askush nuk e di vërtet se çfarë po ndodh nën kapuç,” tha Felix Wong, një postdoktor. në MIT dhe Harvard dhe një nga autorët kryesorë të studimit.
Zbulimi i një kompleksi të ri
Për të përmirësuar përzgjedhjen e barnave të mundshme, studiuesit përdorën tre modele shtesë të të mësuarit të thellë. Këto modele u trajnuan për të vlerësuar toksicitetin e komponimeve në tre lloje të dallueshme të qelizave njerëzore.
Duke integruar këto parashikime të toksicitetit me aktivitetin antimikrobik të përcaktuar më parë, studiuesit vunë në dukje komponime të afta për të luftuar në mënyrë efektive mikrobet me dëm minimal për trupin e njeriut.
Duke përdorur këtë grup modelesh, u ekzaminuan rreth 12 milionë përbërës të disponueshëm në treg.
Modelet identifikuan komponime nga pesë klasa të ndryshme, të kategorizuara në bazë të nënstrukturave kimike specifike brenda molekulave, që shfaqnin aktivitet të parashikuar kundër MRSA.
Më pas, studiuesit morën rreth 280 prej këtyre komponimeve dhe kryen teste kundër MRSA në një mjedis laboratorik. Kjo qasje i bëri ata të identifikonin dy kandidatë premtues për antibiotikë nga e njëjta klasë.
Në eksperimentet që përfshijnë dy modele të miut – një për infeksionin e lëkurës MRSA dhe një tjetër për infeksionin sistemik MRSA – secila prej këtyre përbërësve reduktoi popullsinë MRSA me një faktor prej 10.